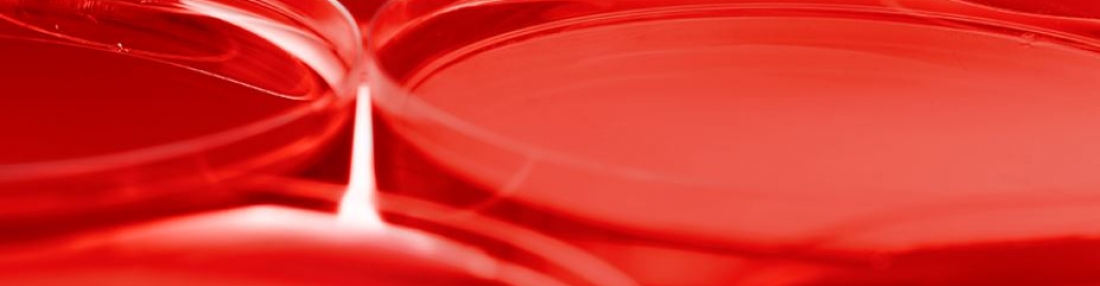
Red Sonnet

Red has no trouble to be
The favorite of people many
It needs not wonder if we it see
and it knows it perks up our antennae.
Red stands for passion, love, and it’s hot
It poo poo’s caution, calm, and patience
It knows full well what it is not
And it will wrest what it must to be in cadence.
Red was stolen by the Soviets
But they fell and have no retort
Now it goes with cheeses and baguettes
And children’s red crayons can get really short.
Red’s the king, the Emperor, and the Queen
No wonder, then, that its complement is modest green.